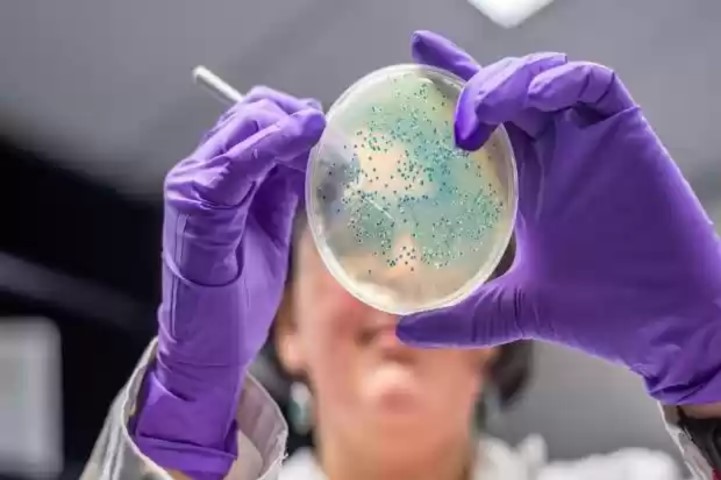

Pilihan
Sebanyak 130 Calon Peserta Didik SMA Negeri Plus Riau Ikuti Psikotest
Dibaca : 124 Kali
Tes Kesehatan di RSUD Arifin Ahmad Berlangsung Cepat dan Tertib
Dibaca : 105 Kali
Melati Wulandari Terpilih dengan Suara Terbanyak 37 Lawan 10
Dibaca : 153 Kali